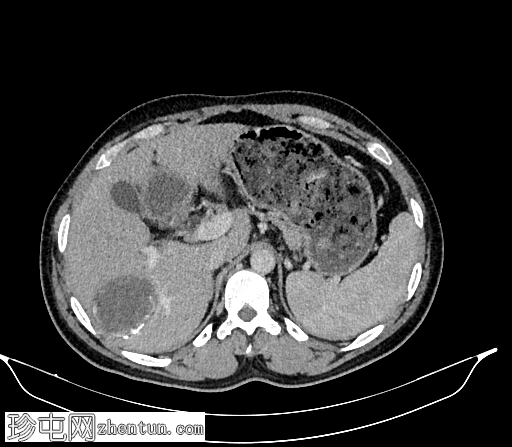
2.png
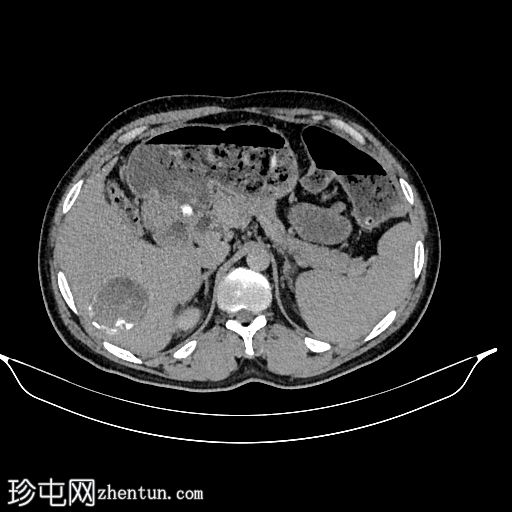
3.jpg

影像表现
未提供。
患者资料
年龄:30岁
性别:男
CT
轴位
平扫

轴位增强扫描(门静脉期)
轴位增强扫描(延迟期)
冠状位增强扫描(门静脉期)

肝脏VII段可见一边界清晰的囊性病变,内部有分隔,囊壁可见钙化。
右肾中央部分(肾门)可见一囊性病变,中心可见基质,周围可见子囊。该病变与肾盂肾盏无交通。病变周围可见两处高密度影,位于上、中肾盏,无法区分是结石还是病变壁钙化。另可见上极肾盏中度扩张。
病例讨论
影像学特征提示肝脏和右肾包虫囊肿。
肾包虫感染是包虫病的一种非常罕见的表现形式;然而,肝脏是最常受累的器官(占病例的76%)。
该患者无随访或组织病理学报告。 |